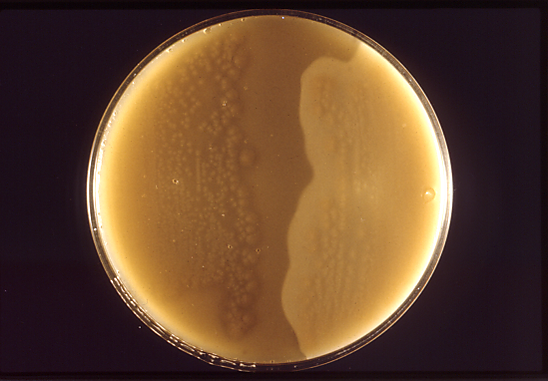

Clostridium perfringens
Clostridium perfringens (лат.) — вид грамположительных, облигатно (строго) анаэробных (за исключением C. perfringens типа A) спорообразующих бактерий рода клостридий. Возбудитель пищевых отравлений человека, один из возбудителей газовой гангрены. Является санитарно-показательным организмом. Открыта в 1892 году Уэлчем и Нетталом.
Что важно знать
| Clostridium perfringens | |
|---|---|
| Научная классификация | |
|
Домен: Тип: Класс: Порядок: Семейство: Род: Вид: Clostridium perfringens |
|
| Международное научное название | |
| Clostridium perfringens (Veillon and Zuber 1898) Hauduroy et al. 1937 |
Биологические свойства
Крупные (0,8—1,5 × 4—8 мкм) полиморфные палочковидные грамположительные бактерии. Споры овальные, расположены центрально либо субтерминально. Неподвижны, в организме человека образуют капсулу. Образуют стабильные L-формы, способные расти на поверхности стекла[1].
Хемоорганогетеротроф, облигатный анаэроб. Растёт на простых питательных средах в анаэробных условиях. На агаризованных средах образуются круглые колонии 1—2 мм в диаметре с гладким или зубчатым краем. Колонии, выросшие в толще агара, имеют чечевицеобразную форму. В жидкой среде — помутнение с дальнейшим просветлением среды и образованием беловатого хлопьевидного осадка. На среде Китт-Тароцци — помутнение с обильным газообразованием. На кровяном агаре образуются круглые гладкие сероватые колонии, постепенно зеленеющие и окружённые зоной гемолиза β-типа. На желточном агаре ввиду образования лецитиназы образуются зоны преципитации. Сбраживают с активным газообразованием глюкозу, лактозу, мальтозу и сахарозу. Используется как суррогат дрожжей для сбраживания теста[2]. Образует масляную кислоту в ходе ацетобутиратного брожения, способен восстанавливать нитраты[3].
В 1989 году было проведено физическое картирование генома C.perfringens с использованием метода пульс-электрофореза[4], в 2001 году была определена нуклеотидная последовательность всего генома C.perfringens штамма 13, этот геном представлен одной кольцевой двуцепочечной молекулой ДНК размером 3031430 п.н. Доля пар Г+Ц составляет 28,6%. Количество открытых рамок считывания составляет 2660. Также имеется плазмида pCP13 размером 54310 п.н., которая содержит 63 открытые рамки считывания[5]. Геном C.perfringens ATCC13124 представлен кольцевой двуцепочечной молекулой ДНК размером 3256683 п.н. и содержит 3015 генов, из них 2899 кодируют белки. Доля пар Г+Ц составляет 28,37%[6]. У C. perfringens штамма E88 геном размером 2799250 п.н. и содержит 2372 открытых рамок считывания[7]. Охарактеризованы гены энтеротоксинов C. perfringens[8], гены токсинообразования могут находиться как на хромосоме, так и на плазмидах[9] и являются транспозибельными элементами[10].
Патогенность
C. perfringens является возбудителем пищевых отравлений человека и одним из возбудителей газовой гангрены. Синтезируют протеиназы, лецитиназу, коллагеназу, гиалуронидазу и другие ферменты агрессивности. Продуцируют также токсины[11][12][13]. α-токсин является фосфолипазой С, обладающей гемолитическими свойствами[14], ε-токсин является белком размером 300 аминокислот, образующий поры в мембранах эпителиоцитов кишечника человека и вызывающий выход ионов K+ и воды из клетки, LD50 для мышей составляет 0,1 мкг на кг веса[15].
См. также
Примечания
Ссылки
- Clostridium perfringens
- Clostridium Prazmowski 1880
- Clostridium perfringens
- FOOD SAFETY FACTS ON CLOSTRIDIUM PERFRINGENS
- The Pathogenic Clostridia © 2008 Kenneth Todar University of Wisconsin-Madison Department of Bacteriology
- Clostridium Perfringens New ways to type strains of a deadly bacteria
- Пищевое отравление, вызванное Clostridium perfringens, Clostridium welchii
- Clostridium perfringens БИОЛОГИЯ И МЕДИЦИНА (недоступная ссылка)